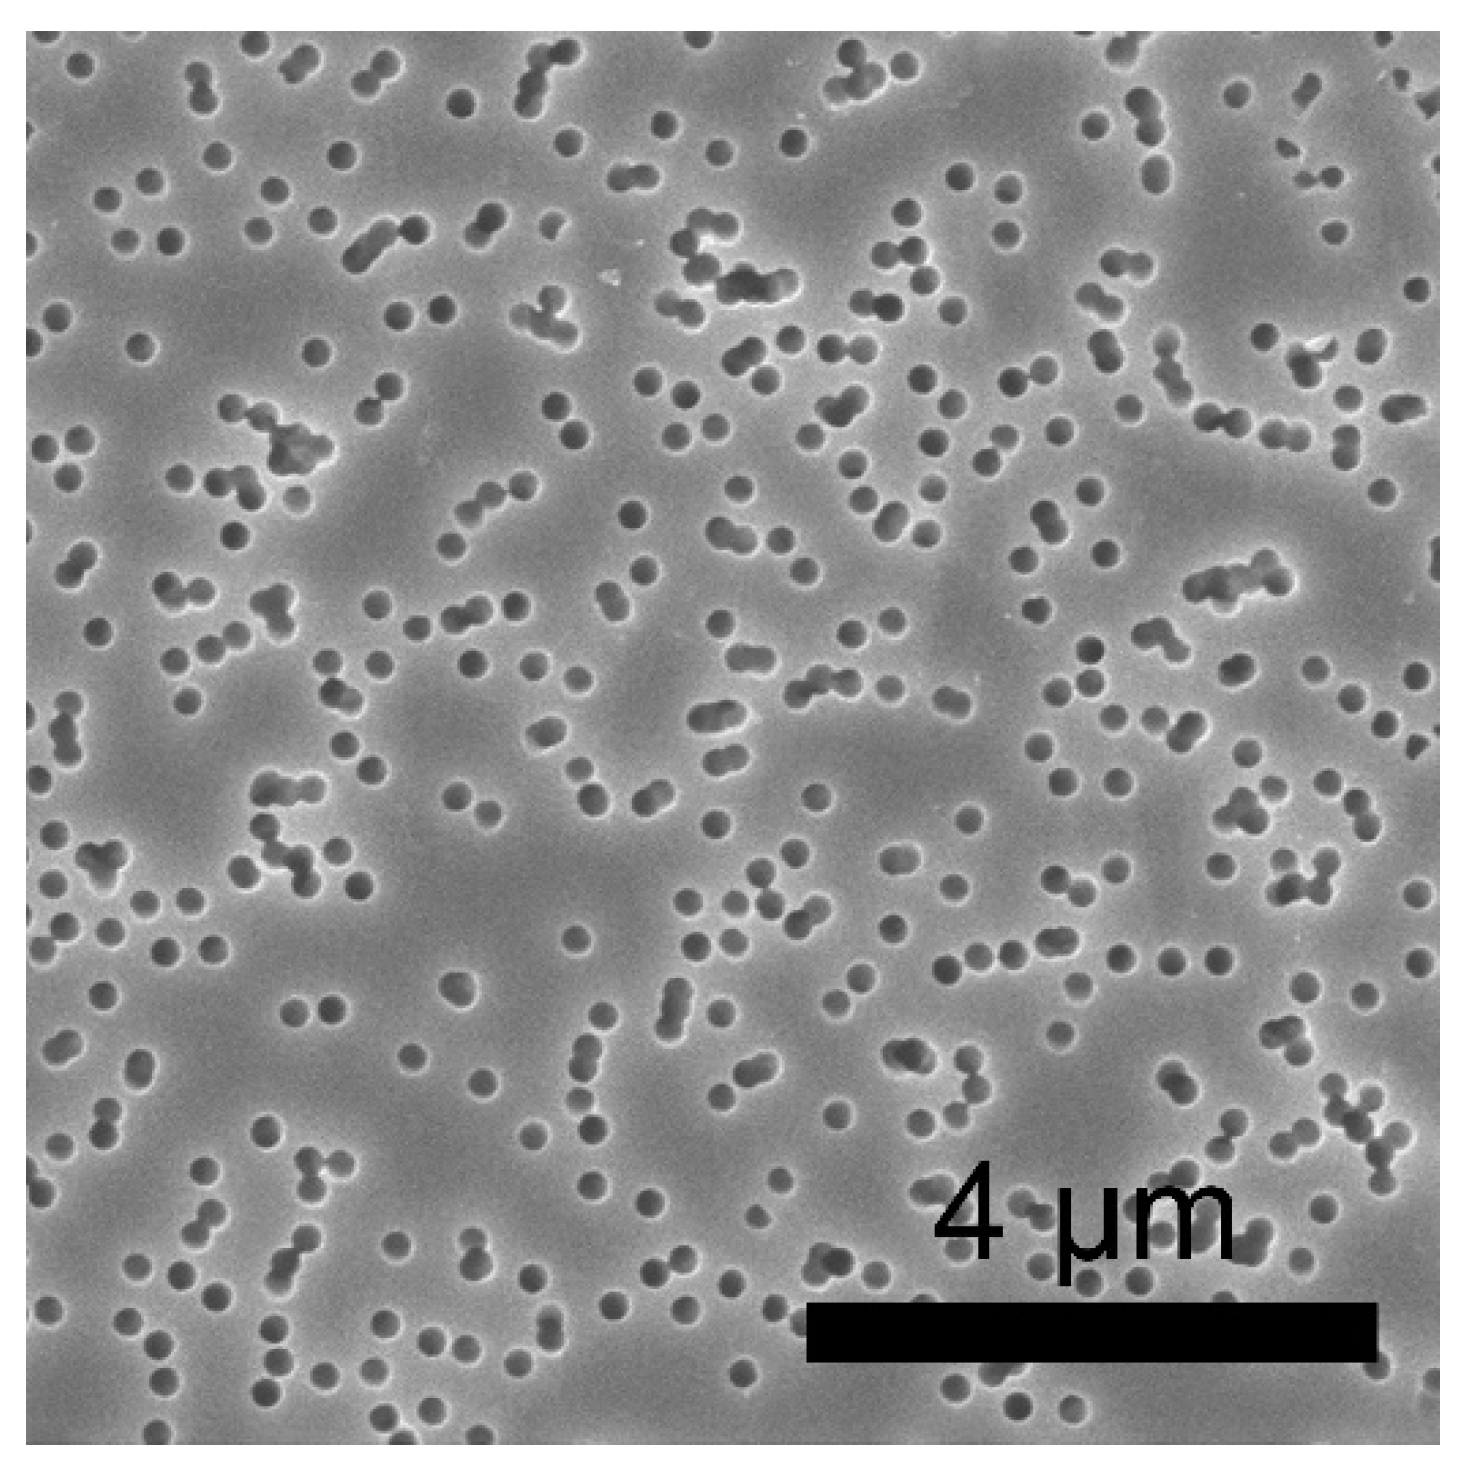
Chemengineering 07 00032 g001

Effect of a Tetraethoxysilane Hydrolysis Reaction Catalyst on the Precipitation of Hydrolysis Products in the Pores of a Polyimide Track Membrane
Abstract
1. Introduction
2. Materials and Methods
2.1. Synthesis of Silica Filler in Acid and Alkaline Media
2.2. Membrane Treatment
2.3. Research Method
3. Results and Discussion
3.1. Spectrum of Light Transmission of Composites Based on Polyimide Track Membranes
3.2. FTIR Spectroscopy of Composites Based on Polyimide Track Membranes
3.3. X-ray Phase Analysis of Silica Filler
3.4. Study of the Degree of Pore Filling
4. Conclusions
Author Contributions
Funding
Data Availability Statement
Conflicts of Interest
References
- Mane, S.M.; Raorane, C.J.; Shin, J.C. Synthesis of Mesoporous Silica Adsorbent Modified with Mercapto-Amine Groups for Selective Adsorption of Cu2+ Ion from Aqueous Solution. Nanomaterials 2022, 12, 3232. [Google Scholar] [CrossRef] [PubMed]
- Es’kin, S.V.; Kosobudskii, I.D.; Zhimalov, A.B.; Ushakov, N.M.; Kul’batskii, D.M.; German, S.V.; Muzalev, P.A. Antireflecting coatings for glass based on monolayers of amorphous silica nanoparticles. Glass Phys. Chem. 2013, 39, 409–413. [Google Scholar] [CrossRef]
- Shahhosseininia, M.; Bazgir, S.; Joupari, M.D. Fabrication and investigation of silica nanofibers via electrospinning. Mater. Sci. Eng. 2018, 91, 502–511. [Google Scholar] [CrossRef] [PubMed]
- Choi, S.S.; Lee, S.G.; Im, S.S.; Kim, S.H.; Joo, Y.L. Silica nanofibers from electrospinning/sol-gel process. J. Mater. Sci. Lett. 2003, 22, 891–893. [Google Scholar] [CrossRef]
- Pavlenko, V.I.; Zabolotny, V.T.; Cherkashina, N.I.; Edamenko, O.D. Effect of vacuum ultraviolet on the surface properties of high-filled polymer composites. Inorg. Mater. Appl. Res. 2014, 5, 2219–2231. [Google Scholar] [CrossRef]
- Pavlenko, V.I.; Cherkashina, N.I. Synthesis of hydrophobic filler for polymer composites. Int. J. Eng. Technol. 2018, 7, 493–495. [Google Scholar] [CrossRef]
- Yastrebinsky, R.N.; Pavlenko, V.I.; Matukhin, P.V.; Cherkashina, N.I.; Kuprieva, O.V. Modifying the surface of iron-oxide minerals with organic and inorganic modifiers. Middle East J. Sci. Res. 2013, 18, 1455–1462. [Google Scholar]
- Matyukhin, P.V.; Pavlenko, V.I.; Yastrebinsky, R.N.; Cherkashina, N.I. The high-energy radiation effect on the modified iron-containing composite material. Middle East J. Sci. Res. 2013, 17, 1343–1349. [Google Scholar]
- Awad, E.M.; Hassan, S.; Bebers, E.; Rammah, Y.S. Strong etching investigation on PADC CR-39 as a thick track membrane with deep depth profile study. Radiat. Phys. Chem. 2020, 177, 109104. [Google Scholar] [CrossRef]
- Apel, P.Y.; Blonskaya, I.V.; Ivanov, O.M.; Kristavchuk, O.V.; Nechaev, A.N.; Olejniczak, K.; Orelovich, O.L.; Polezhaeva, O.A.; Dmitriev, S.N. Do the soft-etched and UV-track membranes actually have uniform cylindrical subnanometer channels? Radiat. Phys. Chem. 2022, 198, 110266. [Google Scholar] [CrossRef]
- Yadegari, A.; Gohs, U.; Khonakdar, H.-A.; Wagenknecht, U. Influence of post-irradiation conditions on crosslinking and oxidation of microporous polyethylene membrane. Radiat. Phys. Chem. 2022, 193, 109997. [Google Scholar] [CrossRef]
- Cherkashina, N.I.; Pavlenko, V.I.; Noskov, A.V.; Shkaplerov, A.N.; Kuritsyn, A.A.; Popova, E.V.; Zaitsev, S.V.; Kuprieva, O.V.; Kashibadze, N.V. Synthesis of PI/POSS nanocomposite films based on track nuclear membranes and assessment of their resistance to oxygen plasma flow. Polymer 2021, 212, 123192. [Google Scholar] [CrossRef]
- Cherkashina, N.I.; Pavlenko, V.I.; Noskov, A.V.; Bondarenko, N.I.; Kuprieva, O.V.; Kashibadze, N.V.; Sidelnikov, R.V.; Klopot, E.P. Gamma radiation attenuation characteristics of composites based on polyimide track membranes filled with nanodispersed Pb. Prog. Nucl. Energy 2021, 141, 103959. [Google Scholar] [CrossRef]
- Sienkiewicz, A.; Czub, P.A. Method of Managing Waste Oak Flour as a Biocomponent for Obtaining Composites Based on Modified Soybean Oil. Materials 2022, 15, 7737. [Google Scholar] [CrossRef]
- Yang, Z.; Kang, G.; Liu, R.; Chen, P. Predicting the mechanical behaviour of highly particle-filled polymer composites using the nonlinear finite element method. Compos. Struct. 2022, 286, 115275. [Google Scholar] [CrossRef]
- Olszewski, A.; Nowak, P.; Kosmela, P.; Piszczyk, Ł. Characterization of Highly Filled Glass Fiber/Carbon Fiber Polyurethane Composites with the Addition of Bio-Polyol Obtained through Biomass Liquefaction. Materials 2021, 14, 1391. [Google Scholar] [CrossRef] [PubMed]
- Alhadhrami, A.; Mohamed, G.G.; Sadek, A.H.; Ismail, S.H.; Ebnalwaled, A.A.; Almalki, A.S.A. Behavior of Silica Nanoparticles Synthesized from Rice Husk Ash by the Sol–Gel Method as a Photocatalytic and Antibacterial Agent. Materials 2022, 15, 8211. [Google Scholar] [CrossRef]
- Vorotyntsev, A.V.; Markov, A.N.; Kapinos, A.A.; Petukhov, A.N.; Pryakhina, V.I.; Nyuchev, A.V.; Atlaskina, M.E.; Andronova, A.A.; Markova, E.A.; Vorotyntsev, V.M. Synthesis and comparative characterization of functionalized nanoporous silica obtained from tetrachloro- and tetraethoxysilane by a sol-gel method. Phosphorus Sulfur Silicon Relat. Elem. 2021, 196, 176–188. [Google Scholar] [CrossRef]
- Bokov, D.O.; Jalil, A.T.; Chupradit, S.; Suksatan, W.; Ansari, M.J.; Shewael, I.H.; Valiev, G.H.; Kianfar, E. Nanomaterial by Sol-Gel Method: Synthesis and Application. Adv. Mater. Sci. Eng. 2021, 2021, 5102014. [Google Scholar] [CrossRef]
- Masalov, V.M.; Sukhinina, N.S.; Emel’chenko, G.A. Colloidal particles of silicon dioxide for the formation of opal-like structures. Phys. Solid State 2011, 53, 1135–1139. [Google Scholar] [CrossRef]
- Han, Y.; Lu, Z.; Teng, Z.; Liang, J.; Guo, Z.; Wang, D.; Han, M.Y.; Yang, W. Unraveling the Growth Mechanism of Silica Particles in the Stöber Method: In Situ Seeded Growth Model. Langmuir 2017, 33, 5879–5890. [Google Scholar] [CrossRef] [PubMed]
- Bashir, S.; Hina, M.; Iqbal, J.; Rajpar, A.H.; Mujtaba, M.A.; Alghamdi, N.A.; Wageh, S.; Ramesh, K.; Ramesh, S. Fundamental Concepts of Hydrogels: Synthesis, Properties, and Their Applications. Polymers 2020, 12, 2702. [Google Scholar] [CrossRef] [PubMed]
- Stöber, W.; Fink, A.; Bohn, E. Controlled growth of monodisperse silica spheres in the micron size range. J. Colloid Interface Sci. 1968, 26, 62–69. [Google Scholar] [CrossRef]
- Lee, D.J.; Lee, H.; Ryou, M.H.; Han, G.B.; Lee, J.N.; Song, J.; Choi, J.; Cho, K.Y.; Lee, Y.M.; Park, J.K. Electrospun Three-Dimensional Mesoporous Silicon Nanofibers as an Anode Material for High-Performance Lithium Secondary Batteries. ACS Appl. Mater. Interfaces 2013, 5, 12005–12010. [Google Scholar] [CrossRef]
- Pickles, C.; Lu, T. Microwave Dewatering of Gibbsite-Type Bauxite Ores: Permittivities, Heating Behavior and Strength Indices. Minerals 2022, 12, 648. [Google Scholar] [CrossRef]
- Rubio, F.; Rubio, J.; Oteo, J.L. A FT-IR study of the hydrolysis of Tetraethylorthoselicate (TEOS). Spectrosc. Lett. 1998, 31, 199–219. [Google Scholar] [CrossRef]
- Potapov, V.V.; Fediuk, R.S.; Gorev, D.S. Obtaining sols, gels and mesoporous nanopowders of hydrothermal nanosilica. J. Sol-Gel Sci. Technol. 2020, 94, 681–694. [Google Scholar] [CrossRef]
- Purnawira, B.; Purwaningsih, H.; Ervianto, Y.; Pratiwi, V.M.; Susanti, D.; Rochiem, R.; Purniawan, A. Synthesis and characterization of mesoporous silica nanoparticles (MSNp) MCM 41 from natural waste rice husk. IOP Conf. Ser. Mater. Sci. Eng. 2019, 541, 012018. [Google Scholar] [CrossRef]
- Verma, J.; Bhattacharya, A. Analysis on Synthesis of Silica Nanoparticles and its Effect on Growth of T. Harzianum & Rhizoctonia Species. Biomed. J. Sci. Tech. Res. 2018, 10, 7890–7897. [Google Scholar] [CrossRef]
- Segal, L.; Creely, J.J.; Martin, A.E.; Conrad, C.M. An Empirical Method for Estimating the Degree of Crystallinity of Native Cellulose Using the X-Ray Diffractometer. Text. Res. J. 2016, 29, 786–794. [Google Scholar] [CrossRef]
- Rotaru, R.; Savin, M.; Tudorachi, N.; Peptu, C.; Samoila, P.; Sacarescu, L.; Harabagiu, V. Ferromagnetic iron oxide–cellulose nanocomposites prepared by ultrasonication. Polym. Chem. 2018, 9, 860–868. [Google Scholar] [CrossRef]

| Component | Vibration Frequency, cm−1 | |
|---|---|---|
| Polyimide | ν C-О | 1320–1210 |
| Unflat δ ОН | 1020–890 | |
| δooр ОН | 750–650 | |
| νas С=О in imides | 1790–1740 | |
| νs С=О in imides | 1730–1690 | |
| Skeletal ν C-C in the benzene ring | 1530–1475 | |
| δ С-С | 1125–1090 | |
| δip С-Н in the benzene ring | 1250–950 | |
| δoop С-Н in the benzene ring | 900–690 | |
| ν C-N polyimides | 1390–1360 | |
| ν Ar-O-Ar | 1290–1230 | |
| Amide IV δ О=С-N interaction of ν C-N and ν C=О | ≈620 | |
| Silica compounds and hydrolysis products | Si-OH | ≈472 |
| Si-O-Si | ≈940 | |
| When binding ethoxy groups Si-O-C | ≈1120 | |
| Valence symmetric Si-O-Si | ≈1045 | |
| Asymmetric vibrations of bridging oxygen Si-O-Si | ≈1080 | |
| Valence C-O | ≈1170 | |
| Deformation symmetric CH3 | ≈1380 | |
| Deformation asymmetric CH3, scissors CH2 | ≈1455 | |
| Deformation H-O-H | ≈1650 | |
| O-H, valence longitudinal Si-OH, H2O | 3490–3100 | |
Disclaimer/Publisher’s Note: The statements, opinions and data contained in all publications are solely those of the individual author(s) and contributor(s) and not of MDPI and/or the editor(s). MDPI and/or the editor(s) disclaim responsibility for any injury to people or property resulting from any ideas, methods, instructions or products referred to in the content. |
© 2023 by the authors. Licensee MDPI, Basel, Switzerland. This article is an open access article distributed under the terms and conditions of the Creative Commons Attribution (CC BY) license (https://creativecommons.org/licenses/by/4.0/).
Share and Cite
Cherkashina, N.I.; Pavlenko, V.I.; Domarev, S.N.; Kashibadze, N.V. Effect of a Tetraethoxysilane Hydrolysis Reaction Catalyst on the Precipitation of Hydrolysis Products in the Pores of a Polyimide Track Membrane. ChemEngineering 2023, 7, 32. https://doi.org/10.3390/chemengineering7020032
Cherkashina NI, Pavlenko VI, Domarev SN, Kashibadze NV. Effect of a Tetraethoxysilane Hydrolysis Reaction Catalyst on the Precipitation of Hydrolysis Products in the Pores of a Polyimide Track Membrane. ChemEngineering. 2023; 7(2):32. https://doi.org/10.3390/chemengineering7020032
Chicago/Turabian StyleCherkashina, Natalia Igorevna, Vyacheslav Ivanovich Pavlenko, Semen Nikolayevich Domarev, and Nikolay Valeriyevich Kashibadze. 2023. "Effect of a Tetraethoxysilane Hydrolysis Reaction Catalyst on the Precipitation of Hydrolysis Products in the Pores of a Polyimide Track Membrane" ChemEngineering 7, no. 2: 32. https://doi.org/10.3390/chemengineering7020032
APA StyleCherkashina, N. I., Pavlenko, V. I., Domarev, S. N., & Kashibadze, N. V. (2023). Effect of a Tetraethoxysilane Hydrolysis Reaction Catalyst on the Precipitation of Hydrolysis Products in the Pores of a Polyimide Track Membrane. ChemEngineering, 7(2), 32. https://doi.org/10.3390/chemengineering7020032

